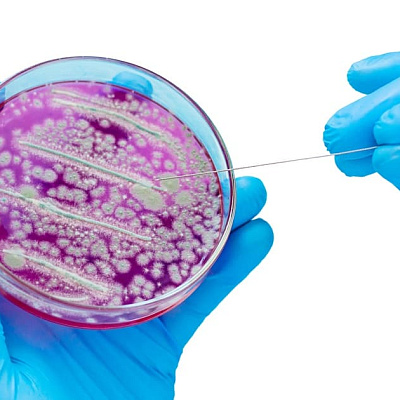

Пиодермия у детей
Пиодермия у детей – это инфекционно-воспалительное заболевание кожи и ее придатков. Проявляет себя формированием гнойничков различного вида. Возбудителями являются стрептококк и стафилококк. Бактерии проникают в орган, распространяются, формируют очаг воспаления. Все это сопровождается явным болевым синдромом, а при больших объемах поражения еще и общей интоксикацией. Медлить нельзя, для предотвращения осложнений придется как можно раньше обратиться к детскому дерматологу. Если нужно вскрыть инфекцию, потребуется еще помощь хирурга. Специалисты проведут осмотр. Назначат обследование. Предложат разные варианты лечения болезни.

Причины пиодермии у детей
Виновниками гнойничковых поражений кожи у детей являются бактерии. В частности, разные штаммы стафилококков и стрептококков. Оба вида микроорганизма очень распространены в окружающей среде. Живут на предметах обихода, продуктах питания, в пыли, почве и даже воздухе. Составляют процент условно-патогенной микрофлоры кожи и слизистых. Поэтому откуда может взяться бактериальное обсеменение, понятно. Другой вопрос, почему оно происходит. Как нормальная флора, количество которой должно находиться под строгим контролем иммунитета, начинает беспорядочно размножаться. Что становится причиной прекращения работы защитных механизмов. Ответ на этот вопрос и является факторами риска заболевания.
Факторы риска
Триггеры пиодермий у детей делят на экзогенные и эндогенные. Первые – это внешние причины, что негативно действует на организм из окружения ребенка. Второе – особенности функционирования отдельных анатомических структур.
Так, к экзогенным факторам нужно отнести:
- частая травматизация кожи;
- мацерация (изменение эпидермиса под действием влаги);
- ношение синтетической одеждой;
- недостаточная гигиена;
- напротив, использование слишком средств для мытья;
- перегревание или переохлаждение тканей (как системно, так и местно);
- ожоги разного размера и локализации;
- повышенное потоотделение;
- чрезмерная активность сальных желез.
Главным эндогенным триггером патологического состояния является иммуносупрессия. Несовершенство иммунной системы становится результатом:
- онкологических заболеваний;
- методов борьбы с раками (химиотерапия, применение цитостатиков, радиоактивное облучение);
- перенесенные хирургические вмешательства;
- тяжелые инфекции в недавнем прошлом;
- гиповитаминоз;
- избыток или дефицит массы тела;
- сопутствующие дерматологические болезни;
- сахарный диабет 1 типа;
- аутоиммунные нарушения;
- нелеченные очаги инфекции.
Благодаря нашим знаниям, полученным на практике, без выявления и устранения провоцирующего фактора, выздоровления добиться практически невозможно. Микробы все равно останутся частью условно-патогенной микрофлоры. На фоне антибиотикотерапии меньше их станет, но ненадолго. Быстро концентрация восстановится. Высыпания через неделю-другую после завершения курса этиотропных препаратов появятся снова.
Поэтому важный аспект диагностики и лечения болезни – не столько подавление роста бактерий, но и устранение причинного фактора. Как только иммунная система начинает нормально работать, контролирует условно-патогенную флору и концентрацию отдельных ее составляющих или исчезают экзогенные триггеры, пиодермия разрешается.

Патогенез
Механизм развития разный, зависит от внутренних и внешних провокаторов.
Что касается экзогенных факторов, главную роль играет повреждение кожи. Целостность эпидермиса, который в норме должен защищать орган от разного вида воздействия, в том числе бактерий, нарушается. Микроорганизмы попадают на поврежденный участок. Без препятствий активно размножаются, формируют воспаление.
Большая часть патогенеза для эндогенных триггеров описана выше. Иммунитет ослаблен, не контролирует размножение условно-патогенной флоры. Бактерии свободно делятся, опять же формируют гнойник.
Встречается сочетание обоих вариантов патогенеза. К примеру, у ребенка есть и ожог, и системное заболевание. Оба механизма довольно сильно усложняют лечение маленького пациента, ухудшают течение и прогноз.
В любом случае в ответ на усиленное размножение патогенов реагирует иммунитет. Непосредственно в очаг воспаления мигрируют защитные клетки, пробуют бороться с бактериями. При благоприятном исходе все получается, и процесс ограничивается капсулой, изменения обнаруживаются только местно. Напротив, неблагоприятное течение – это массивное проникновение возбудителей в системный кровоток и общая интоксикация, вплоть до сепсиса. На первый план в таких случаях выходит борьба уже не с местной инфекцией, а с развивающейся полиорганной недостаточностью.
Классификация
Главная систематизация детской пиодермии основывается на причине ее возникновения. Так, специалисты выделяют всего 2 группы:
- стафилодермии;
- стрептодермии.
Стафилодермии, в свою очередь, бывают:
- поверхностные (остиофолликулит, фолликулит, везикулопустулез, эпидемическая пузырчатка новорожденных);
- глубокие (фурункул, карбункул, абсцесс, псевдофурункулез, гидраденит).
Стрептодермии также разделяются на следующие группы:
- поверхностные (импетиго, в том числе щелевидное, паронихия, интертригинозная стрептодермия);
- глубокие (вульгарная эктима).
Симптомы пиодермии у ребенка
Форм пиодермии много. Есть общие для всех системные и местные проявления, особенные для каждые патологии отдельные признаки.
Основной симптом, который родители замечают, с которым обращаются к врачу – это изменения кожи. На первично неизмененном участке появляется очаг гиперемии, отек тканей. Позже в центре размягчение, флюктуация. Внешне это выглядит как красный очаг, разного по размеру диаметра, с желтоватой покрышкой в центре.
Системная интоксикация случается только при больших объемах поражения. Температура тела критично высокая, 38-39, даже до 40 градусов. Лимфатические узлы увеличены в размере, болезненны. Беспокоят типичные для такой температуры головная боль, слабость, недомогание.
Есть ряд особенностей течения в зависимости от вида патогена.
Стрептококки распространяются по поверхности кожи. Преимущественно поражают эпидермис, редко проникая вглубь. Отсюда ведущим элементом сыпи становится фликтена – пузырь с гнойным содержимым и очень дряблой оболочкой. Стоит ее проколоть и убрать гной, как болезнь разрешится. Ранка затянется.
Со стафилококками по-другому. Здесь уже инфекция распространяется преимущественно вглубь, в придатки кожи (железы сальные и потовые, волосяные фолликулы). В связи с этим выделяют различные нозологические формы.
Из наиболее часто встречающихся стафилодермий стоит упомянуть:
- Везикулопустулез – это вариант пиодермии новорожденного ребенка, возникает на 5-7 день жизни. Особенно часто у недоношенных детей, с сопутствующими болезнями. В кожных складках, на голове и ягодицах возникают розовые папулы. Через пару дней превращаются в везикулы с серозным содержимым. Еще немного и в пустулы с гнойниками в центре. Дальше варианта два: самостоятельное вскрытие очага с формированием эрозий или подсыхание через корку. Разрешаются элементы бесследно. Системные проявления либо отсутствуют, либо слабо выражены.
- Остиофолликулит и фолликулит. Обе патологии затрагивают волосяной фолликул. В первом случае вовлекается только его устье, во втором – средние и глубокие отделы. Клиника типична. На неизменной коже на руках и ногах, на лице и шее развиваются очаги. Боль, отек, покраснение, затем пустула. Отличительная черта: из центра гнойника выходит волосок. Разрешается образование за пару дней коркой. Может оставить после себя небольшую гиперпигментацию, но, в целом, проходит бесследно.
- Эпидемическую пузырчатку новорожденных. Возникает на 3-5 сутки жизни ребенка, поражает область пупка, конечности, спину и складочки кожи. На измененных участках определяются поверхностные, ненапряженные пузыри, заполненные гноем. По размеру от нескольких мм до пары сантиметров. После вскрытия на месте поражения остается эрозия. Заживает вторичным натяжением. Приблизительно у половины больных к местной интоксикации добавляются системные проявления. Но не так, чтобы критично. Температура максимум 38. Есть воспалительные изменения в анализе крови.
- Псевдофурункулез (псевдо-, так как в отличие от классических фурункулов нет некротического стержня и инфильтрации окружающих гнойник тканей). Этот вариант пиодермии поражает детей в первые пару месяцев жизни. Затрагивает всю часть потовой железы. По задней поверхности туловища, от затылка до бедер, появляются разного размера папулы. По мере развития в их центре формируется феномен флюктуации. Врач вскрывает очаг, получает гной. Общее состояние сразу улучшается. Температура падает, появляется аппетит, ребенок становится активным.
Вторая группа болезней, проявляющих себя гнойничковыми высыпаниями на теле – стрептодермии:
- Стрептококковое импетиго – разновидность пиодермии лица и головы у детей. Сначала появляются красноватые пятна, затем на их месте заполненные серозным или серозно-гнойным содержимым фликтены. По краю красноватый венчик. Элементы вскрываются, иссыхают. Приблизительно за неделю на месте первичного элемента остается желтоватого цвета корка.
- Буллезное импетиго. По клинике напоминает предыдущую форму с той разницей, что вместе со фликтенами появляются напряженные пузыри. Вскрываются, оставляют после себя эрозии. Разрешаются патологические элементы эрозиями, заживают вторично.
- Щелевидное импетиго. Фликтены определяются в уголках рта, глаз, на крыльях носа. Быстро вскрываются, оставляют после себя эрозии и трещины под корками. Окружающая кожа сухая, умеренно отечна.
- Турниоль (панариций) – пиодермия у детей на руках, поражает ногтевые фаланги. Клиника типична, с гнойниками и локальным болевым синдромом, локальным отеком тканей. При вскрытии элемента врач получает гной.
- Интертригинозная стрептодермия. Возникает в кожных складках. Ввиду механического раздражения одеждой элементы вскрываются. Остаются эрозии с мокнущей поверхностью и фестончатыми краями, в глубине трещины. Заживают образования плохо.
- Папуло-эрозивная стрептодермия. Поражает половые органы, нижние конечности. На первично неизмененных участках появляются цианотичные узлы, сверху которых привычные для данного возбудителя фликтены. Вскрываются, оставляют после себя эрозии.
- Вульгарная эктима – самая тяжелая форма стрептодермии. Протекает с образованием на коже язвенных дефектов. Сначала пустулы, затем желтые корки. Под ними язва. За несколько недель все это разрешается. Рана очищается от гноя. Заживает рубцом.
- Рожа – стрептококковая пиодермия, вовлекающая в себя кожу и подкожно-жировую клетчатку. Особенно тяжело протекает у новорожденных, детей младшего возраста. Дебютирует с очага воспаления в области пупка. Чуть горячее на ощупь, плотное, красное пятно с нечеткими границами. Быстро распространяется вверх и вниз. Сильно страдает общее состояние малыша. Температура высокая, пациент не ест, много спит. Много срыгивает. У ослабленных детей болезнь приводит к септическим осложнениям.
У пациентов постарше клиника рожи мало чем отличается от таковой у взрослых. Эритематозная форма: ярко-красные очаги, по типу языков пламени. Кожа горячая, отечная, с характерным блеском. Буллезная – к прочим проявлениям добавляются буллы, большие пузыри. Флегмонозная – расправляет подкожно-жировую клетчатку. Гангренозная затрагивает фасции и мышцы. Логично, что все это проявляет себя выраженной общей интоксикацией. Пациенту нужно как можно раньше обратиться к врачу.
И, наконец, третья причина пиодермии у ребенка – сочетание стафилококковой и стрептококковой инфекции, вульгарное импетиго. Именно эта патология осложняет течение большинства зудящих дерматозов. Симптоматика поэтапная: фликтена, дальше гнойное содержимое. Разрешается плотными «медовыми» корками. Рубцов после заживления не остается.
Осложнения
Осложнений гнойничковых высыпаний у детей долго ждать не придется. Во-первых, кожа очень мягкая, тонкая, нежная. Во-вторых, все слои отлично кровоснабжаются, активно работает система лимфоотведения. И в-третьих, факторы иммунной защиты работают не так совершенно как у взрослых людей. Итог: быстрое развитие инфекции и высокий темп ее распространения.
Из числа частых осложнений нужно выделить:
- Лимфангит – воспаление распространяется по ходу лимфатического сосуда. В месте проекции его на кожу полоса отека, покраснения, локальной болезненности.
- Лимфаденит – воспаление лимфатического узла. На серозной стадии образование увеличивается в размере, по консистенции плотное. Пальпация сопровождается выраженным болевым синдромом. На этапе нагноения кожа красная, горячая на ощупь, определяется отек, флюктуация.
- Из более опасных осложнений стоит упомянуть распространение инфекции. Микроорганизмы вместе с кровотоком разносятся по организму. Обуславливают синдром системной воспалительной реакции, недостаточность жизненно важных органов и тканей.
Единственный вариант предотвратить осложнения: не ждать, пока гнойник сам пройдет, или появятся еще несколько, а при первом же изменении кожи обратиться к врачу.
Диагностика пиодермии у детей
При подозрении на пиодермию у ребенка диагностику нужно начать как можно раньше. На первоначальном этапе можно пригласить педиатра на дом или записаться на прием в клинику. Специалист собирает жалобы, изучает анамнез заболевания и жизни. Проводит осмотр. На основании этого выставляет предварительный диагноз. Дальше, исходя из сложности стояния, назначает лечение или направляет пациента к узким специалистам.
Для дифференциальной диагностики пиодермии у детей назначают:
- Лабораторные анализы. Подтверждают факт бактериальной инфекции: ускорение скорости оседания эритроцитов, повышение количества лейкоцитов, сдвиг формулы влево.
- Дерматоскопия. Доктор проводит прицельный осмотр патологических очагов и элементов с помощью специального прибора под многократным увеличением.
- Исследование материала на флору и чувствительность к антибиотикам. Врач получает секрет с пустулы, направляет его к специалистам. Микробиологи изучают, какая бактерия виновата в болезни, какими препаратами на нее воздействовать.
Помимо тестов для выявления собственно пиодермии, потребуется еще ряд исследований для изучения ее причины. Объем диагностики в каждом случае доктор определяет индивидуально.
Гнойничковые высыпания при разных инфекционных агентах могут быть схожи между собой. Окончательно понять природу поражения можно только после получения результата микробиологии. Не пытайтесь заниматься самолечением до определения точной причины кожных проявлений.
Лечение пиодермии у детей
Лечение поражения кожи комплексное: нужно устранить первопричину, триггер, остановить развитие воспитательного процесса. Только при воздействии на все аспекты можно добиться выздоровления. Иначе рецидива не миновать.
Дерматологи обычно наблюдают амбулаторно. Назначают крема, мази, порошки и растворы, системные средства. Наблюдают за динамикой. Госпитализация нужна только в сложных случаях, когда сильно выражена общая интоксикация или у ребенка есть сопутствующие болезни, за которыми надо наблюдать.
У хирургов все по-другому. Совсем маленьких детей они госпитализируют. Операцию амбулаторно не выполнишь, да и перевязки нужны. Если гнойник небольшой, и родитель сможет дальше приводить пациента в клинику, полечить можно амбулаторно.
Итак, консервативное лечение основывается на местном разрешении элементов. Врач назначает антисептики (хлоргексидин, перекись водорода, раствор марганцовки) или антибактериальные средства для локального применения (болтушки, мази, спреи, порошки). Родитель ежедневно обрабатывает элементы сыпи назначенными средствами. Пустулы вскрываются или подсыхают.
Системное лечение высыпаний кожи нужно отнюдь не каждому ребенку. Несмотря на то что инфекция бактериальная, без антибиотиков можно обойтись. Если нет общей интоксикации, температура в пределах нормы, ребенок неплохо себя чувствует и анализы не выходят за референтные значения, смысла в назначении нет. Обратная ситуация, когда есть хоть один из перечисленных факторов, специалисту ничего не остается, кроме как назначить антибиотик внутрь. Сначала широкого спектра, затем по результатам полученного посева.
Хирургическое лечение проводит детский хирург. Под местным или общим обезболиванием он вскрывает очаг поражения. Эвакуирует гной, очищает полость от нежизнеспособных тканей. Далее промывает рану растворами антисептиков и устанавливает дренаж. За несколько дней последующих перевязок очаг воспаления очищается, после эпителизируется. Решение о необходимости дополнить хирургию антибиотиками, врач принимает индивидуально.
По мере прохождения всего перечисленного лечения системная интоксикация разрешается. Местные элементы больше не появляются, уже имеющиеся уходят. Осталось сделать так, чтобы болезнь не вернулась.
К направлениям терапии для скорейшего выздоровления, предотвращения рецидива стоит отнести:
- лечение основного заболевания;
- устранение эндогенного триггера;
- иммуностимуляция (витамины, протеолитические ферменты, сеансы ультрафиолетового или лазерного облучения крови, иммуноглобулины);
- физиотерапия после очищения раны от гноя для стимуляции регенерации тканей;
- соблюдение диеты (исключение сладостей, жирных, соленых продуктов).
Прогноз и профилактика
Прогноз благоприятный. При условии соблюдения всех рекомендаций врача за неделю-две можно будет добиться полного выздоровления. Исключение триггеров предотвратит рецидив пиодермии.
Профилактика включает в себя:
- обработку ран растворами антисептиков;
- исключение травм кожи;
- регулярную гигиену;
- использование подходящих средств для мытья тела;
- укрепление иммунитета;
- правильное питание;
- регулярную физическую активность;
- выбор одежды из натуральных тканей;
- ограничение контакта с больными людьми;
- лечение сопутствующих хронических заболеваний.
Источники
- Общероссийская общественная организация "Российское общество дерматовенерологов и косметологов". Клинические рекомендации. Пиодермии. 2025.
- Н.Г. Кочергина, О.Ю. Олисова, «Клиническая хрестоматия по детской дерматологии», 2016.
- И.А. Горланов, Л.М. Леина, И.Р. Милявская, Д.В. Заславский, О.В. Оловянишников, С.Ю. Куликова. «Детская дерматовенерология», 2017.

Ответы на вопросы
Пиодермия у ребенка - это заразно?
Пиодермия – это инфекционное заболевание. Его виновниками являются бактерии. Следовательно, один ребенок может заразиться от другого. Обычно это контактно-бытовой путь передачи, через предметы обихода или прямой, через прикосновения. Увеличивается риск заражения у детей с сопутствующими экзогенными и эндогенными триггерами.
У новорожденного ребенка гнойнички на лице. Можно прижечь их зеленкой?
Нет, до осмотра детского врача категорически нельзя. Причин запрета сразу несколько. Во-первых, это может быть младенческое акне – временное состояние, вариант нормы. Во-вторых, зеленка делается на основе спирта, а кожа у новорожденных очень нежная. Можно легко дойти до ожога. К тому же яркий по цвету раствора помешает врачу оценить сыпь. В-третьих, смысла такого лечения нет. Серьезное заболевание от такой терапии не разрешится и может усугубить процесс.
Можно ли купать ребенка с пиодермией?
Нет, пару дней контакт с водой лучше ограничить. Особенно если речь идет об острой форме. Стоит постараться не мочить рану. Если нужно, разрешена только местная обработка жидкими антисептиками. Также важно не использовать мочалку и моющие средства. Болезнь от этого будет только развиваться. Остальные правила ухода за кожей в момент рецидива и после достижения подострой стадии лучше обсудить с лечащим врачом.
Чем можно помазать гнойник, чтобы он поскорее вскрылся?
Ничем. Так делать категорически запрещено. Вскрыть гнойник мало, нужно его еще очистить от гноя, некротизированных тканей и дренировать. Никакая мазь с этим не справится. Максимум, что она сделает – это «прорвет» очаг воспаления. Часть гноя выйдет, а оставшиеся пораженные ткани буквально за день заново воспроизведут патологический субстрат. Поражение кожи вернется к первоначальному состоянию. Смысла от терапии нет.
Заболевания по направлению Детский дерматолог
Лицензии

Мы осуществляем деятельность на основании медицинских лицензий в соответствии с рекомендациями Минздрава